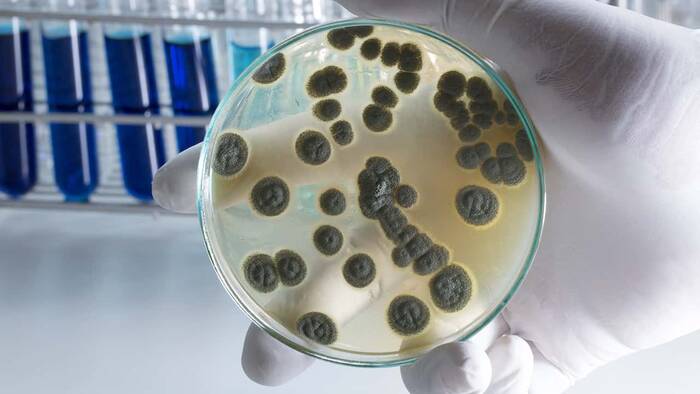
Qué es la penicilina 1 Historia de la penicilina

La penicilina es un antibiótico betalactámico que actúa mediante la activación de enzimas autolíticas que destruyen la pared celular en algunas bacterias. Es decir que se usa para tratar y prevenir ciertas infecciones provocadas por bacterias.
Lea TAMBIÉN: QUÉ ES LA FECUNDACIÓN
La penicilina pertenece a una clase de medicamentos llamados penicilinas y es experta en la eliminación de bacterias que causan infecciones en el ser humano.
Dicho antibiótico es destinado para tratar infecciones fuertes, por lo tanto no funcionará para resfriados, influenza u otras infecciones virales.
Se dice que usar penicilina cuando no se necesita, incrementa el riesgo de contraer una infección más adelante y esta será imposible atacarla con el mismo antibiótico.
La penicilina fue uno de los primeros antibióticos que se inventaron y también uno de los que más se utilizaron en todo el mundo.
Durante años y gracias a los descubrimientos de Alexander Fleming, los antibióticos a base de penicilina han salvado la vida de millones de personas. Razón por la cual esta invención constituye una de las más importantes de la historia.
Historia de la penicilina
La penicilina constituye uno de los primeros antibióticos utilizados en la historia para tratar infecciones y otras enfermedades serias. En la actualidad, todavía se utiliza de forma regular en la medicina moderna.
Todas y cada una de las penicilinas son antibióticos ya sea β-lactámicos (beta-lactámicos), es decir, moléculas antibióticas con núcleo β-lactámico.
Aunque parece que existe una sola, la verdad es que hay diferentes tipos de penicilina, cada una de ellas reacciona contra las bacterias en diferente grado. Algunos de los tipos de penicilina más empleados son: ampicilina, amoxicilina, flucloxacilina, fenoximetilpenicilina.
En cuanto a su historia, la penicilina fue el primer antibiótico empleado en medicina y su descubrimiento fue hecho por Alexander Fleming.
El descubrimiento de la penicilina ocurrió de una forma casual y fue relatada por el propio Fleming. El 28 de septiembre de 1928, el científico se encontraba estudiando cultivos de bacterias en el sótano del laboratorio del hospital St. Mary, en Londres.
Fleming se encontraba estudiando bacterias de estafilococo pero tras un descanso de un mes, dejó una placa de petri que contenían bacterias cerca de una ventana abierta. Luego de retomar sus investigaciones, encontró que su experimento había estropeado las muestras. Es decir que las muestran estaban contaminadas con una especie de moho que había entrado con el viento.
Fleming en lugar de tirar su experimento, procedió a colocar la placa de petri en el microscopio.
Lo que observó fue que no solo el moho había contaminado todo el contenido de la placa, sino que alrededor de éste, había una zona limpia en la que el moho había matado a las bacterias.
La penicilina como un gran descubrimiento

Luego de identificar el moho como hongos de penicillium, Fleming no tuvo otro argumento más que plantearse que el llamado penicillium, eliminaba las mortales bacterias staphylococcus de una vez por todas.
Con el pasar del tiempo, se perdió la confianza esto debido a que habían dudas sobre si el hongo realmente podía usarse como antibiótico y cuán seguro era para el cuerpo humano.
Pero las numerosas investigaciones, pruebas y ensayos clínicos le dieron la seguridad necesaria para desarrollar y completar el descubrimiento. Si era posible usar penicilina en humanos.
En la búsqueda de afirmar el descubrimiento y otorgar confianza, muchos colegas universitarios lo apoyaron, entre ellos, Sir Howard Florey y Ernst Chain, ambos de la Universidad de Oxford.
Luego que los colegas de Fleming dieron el visto bueno a la penicilina y confirmaran que podía utilizarse perfectamente en los humanos como un antibiótico, se probó por primera vez en humanos.
Orvan Hess y Bumstead Juan fueron las primeras personas en utilizar la penicilina como antibiótico y los resultados fueron un éxito. Desde entonces, los antibióticos de penicilina han logrado salvar a una gran cantidad de vidas a nivel mundial.
Usos

La penicilina es usada para una gran infinidad de infecciones entre las que destacan neumonía y otras infecciones del tracto respiratorio.
También puede ser utilizada para tratar la fiebre escarlata y las infecciones de oído, piel, encías, boca e infecciones de garganta.
También se usa para prevenir que regrese la fiebre reumática, que es una enfermedad que puede desarrollarse después de una infección de fiebre escarlata o de estreptococo en la garganta.
La penicilina también es usada para tratar ciertas infecciones de la piel causadas por ántrax.
Algunas veces en conjunto con otros medicamentos se utiliza para tratar la difteria.
La penicilina también se utiliza para prevenir infecciones en las válvulas del corazón en algunos pacientes que tienen una condición del corazón y que necesitan algún procedimiento dental o del tracto respiratorio superior.
Antes de utilizar este tipo de antibióticos es necesario consultar a su médico. Recuerde que bajo ningún concepto es aceptable la automedicación. Cualquier duda que tenga al respecto consulte a su médico.




